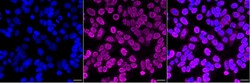
Invitrogen PTBP1 Recombinant Rabbit Monoclonal Antibody (24GB1095) 20 &mu;L;

missing translation for 'onlineSavingsMsg'
Learn More
Learn More
Invitrogen™ PTBP1 Recombinant Rabbit Monoclonal Antibody (24GB1095)
Rabbit Recombinant Monoclonal Antibody
Marke: Invitrogen™ MA557653
Dieser Artikel kann nicht zurückgegeben werden.
Rückgaberichtlinie anzeigen
Beschreibung
PTBP1 Recombinant Monoclonal Antibody for Western Blot, Flow
This gene belongs to the subfamily of ubiquitously expressed heterogeneous nuclear ribonucleoproteins (hnRNPs). The hnRNPs are RNA-binding proteins and they complex with heterogeneous nuclear RNA (hnRNA). These proteins are associated with pre-mRNAs in the nucleus and appear to influence pre-mRNA processing and other aspects of mRNA metabolism and transport. While all of the hnRNPs are present in the nucleus, some seem to shuttle between the nucleus and the cytoplasm. The hnRNP proteins have distinct nucleic acid binding properties. The protein encoded by this gene has four repeats of quasi-RNA recognition motif (RRM) domains that bind RNAs. This protein binds to the intronic polypyrimidine tracts that requires pre-mRNA splicing and acts via the protein degradation ubiquitin-proteasome pathway. It may also promote the binding of U2 snRNP to pre-mRNAs. This protein is localized in the nucleoplasm and it is also detected in the perinucleolar structure. Alternatively spliced transcript variants encoding different isoforms have been described.
Spezifikation
| PTBP1 | |
| Recombinant Monoclonal | |
| Unconjugated | |
| PTBP1 | |
| 57 kDa RNA-binding protein PPTB-1; AA407203; AL033359; Heterogeneous nuclear ribonucleoprotein I; heterogeneous nuclear ribonucleoprotein polypeptide I; hnRNP I; HNRNPI; HNRNP-I; HNRPI; MGC10830; MGC8461; polypyrimidine tract binding protein (heterogeneous nuclear ribonucleoprotein I); polypyrimidine tract binding protein 1; polypyrimidine tract-binding protein; polypyrimidine tract-binding protein 1; polypyrimidine-tract binding protein; pPTB; PTB; PTB-1; PTB2; PTB3; PTB4; PTBP1; PTB-T; Pybp; Pybp1; Pybp2; pyrimidine binding protein 1; pyrimidine binding protein 2; RNA-binding protein | |
| Rabbit | |
| Affinity chromatography | |
| RUO | |
| 19205, 29497, 5725 | |
| -20°C | |
| Liquid |
| Flow Cytometry, Western Blot, Immunocytochemistry | |
| 24GB1095 | |
| PBS with 50% glycerol and 0.02% sodium azide; pH 7.4 | |
| P17225, P26599, Q00438 | |
| PTBP1 | |
| A synthesized peptide derived from human PTBP1 (aa 20-68). | |
| 20 μL | |
| Primary | |
| Human, Mouse, Rat | |
| Antibody | |
| IgG |
Berichtigung von Produktinhalten
Bitte geben Sie uns Ihr Feedback zu den Produktinhalten, indem Sie das folgende Formular ausfüllen.
Name des Produkts
Haben Sie Verbesserungsvorschläge?Übermitteln Sie eine inhaltliche Korrektur